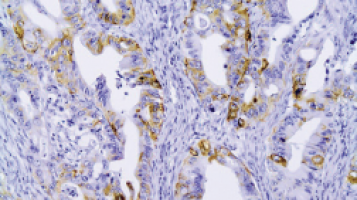
Simple tumour biomarker test predicts which stomach cancer patients will respond to immunotherapy

Researchers from Zhejiang Cancer Hospital and Peking University have discovered a new biomarker that can predict which gastric cancer patients will benefit from immunotherapy before surgery.
Their findings, recently published in Science Bulletin, could help doctors select the most appropriate treatment for patients with locally advanced gastric cancer.
Gastric cancer ranks as the fifth most common cancer and fourth leading cause of cancer death globally, with China bearing nearly half of the worldwide burden.
While immune checkpoint inhibitors have shown promise in treating advanced gastric cancer, only a subset of patients respond well to these therapies.
Existing biomarkers like PD-L1 expression have limitations due to technical complexity and inconsistent assessment.
The research team conducted comprehensive single-cell RNA sequencing on tumour samples from patients receiving neoadjuvant immunotherapy.
They discovered that tumour-specific MHC-II (tsMHC-II) expression strongly correlated with treatment response.
Patients with tsMHC-II-positive tumours showed significantly higher rates of pathological complete response (36.84% versus 11.11%) and major pathological response (63.16% versus 25.93%) compared to those with tsMHC-II-negative tumours.
To validate these findings, researchers conducted a prospective clinical trial with 30 patients selected specifically for having tsMHC-II-positive tumours.
These patients achieved remarkable response rates: 36.67% attained pathological complete response and 66.67% achieved major pathological response—significantly higher than typically observed in unselected populations.
The study also revealed that tsMHC-II expression can be easily assessed using standard immunohistochemistry techniques available in most pathology laboratories, making it more practical and reliable than current biomarker tests.
Unlike PD-L1 assessment, which often shows poor agreement between pathologists, tsMHC-II evaluation provides clear and consistent results.
Mechanistic studies showed that interferon-gamma signalling upregulates MHC-II expression in tumour cells, enhancing immune recognition and response to immunotherapy.
This discovery provides not only a practical predictive tool but also insights into improving treatment strategies for gastric cancer patients.
"This biomarker could transform how we select patients for neoadjuvant immunotherapy," Professor.
Xiangdong Cheng said, one of the study's corresponding authors.
"By identifying patients most likely to benefit, we can improve outcomes while sparing non-responders from unnecessary treatments and side effects."
The researchers are now planning larger multi-centre trials to further validate tsMHC-II as a predictive biomarker and explore its potential application in other cancer types.
Institution Profile
Founded in 1963, Zhejiang Cancer Hospital (ZJCH) is one of China’s pioneering specialised cancer centres and a national leader in oncology care, research, and public health.
As one of the first four dedicated cancer hospitals established in the People’s Republic of China, ZJCH has played a pivotal role in shaping the nation’s cancer control strategy.
Recognised with the highest national rating (“Grade A+”) in the Chinese National Performance Assessment for Tertiary Public Hospitals for six consecutive years, ZJCH exemplifies excellence in clinical outcomes, patient care, scientific research, and healthcare system innovation.
The hospital serves as the Provincial Centre for Cancer Prevention, Control, and Quality Assurance, coordinating a robust three-tier network that integrates provincial, municipal, and county-level institutions to advance equitable, high-quality cancer care across Zhejiang Province—a model with potential relevance for regional cancer control programmes worldwide.
Source: Science China Press